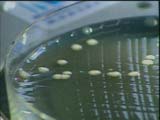

L' EAU QUI TUE Médecine - Santé 29min FRANCE
|
En France, chaque annķe, plus de 500 personnes sont contaminķes par la bactķrie : 70 Ó 80 personnes perdent la vie des suites de cette maladieģ Poutant la lķgionellose est taboue. La bactķrie dķrange car traiter les problĶmes de lķgionelles co¹te cher, trĶs cherģ Etķ 1998, en pleine Coupe du Monde, 20 personnes sont contaminķes par la bactķrie : 11 franńais, 7 anglais et 1 danois. Quatre d'entre-elles dķcĶdent, des passants qui ont commis l'imprudence de se promener en toute insouciance dans les rues de la Capitaleģ L'une des sources de contamination ( la plus importante ) vient des tours aķrorķfrigķrantes d'un grand immeuble parisien. Mais 3 ans aprĶs les faits, aucun coupable, aucune sanction, aucune enquĻte rendue publique. Et ceux qui osent briser la loi du silence aujourd'hui risquent de le payer cherģ |
® MIF-SCIENCES - Tous droits rķservķs - Renseignements sur demande